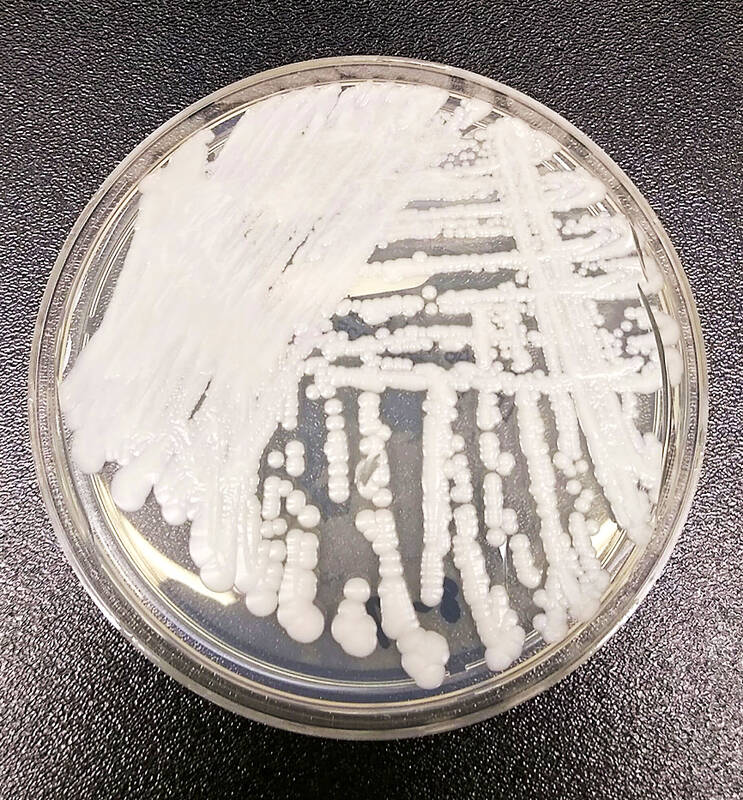

Three cases of Candida auris, a fungus that can cause a yeast infection known as candidiasis in humans, have been reported in Taiwan over the past few years, but they did not display drug resistance, Centers for Disease Control (CDC) Deputy Director-General Philip Lo (羅一鈞) said yesterday.
Lo made the statement at a news conference in Taipei, one day after the Washington Post reported that the potentially deadly fungus is spreading in US hospitals.
The fungus was first discovered in Japan in 2009 and poses a danger to immunocompromised people, with an estimated mortality rate of 30 to 60 percent, Lo said.
Photo: AP
Most people infected in the US were hospital patients breathing through respirators or undergoing dialysis, he said, adding that the condition has affected people of all ages from newborns to the elderly.
The first Taiwanese case, reported in April 2018, was a 50-year-old resident of southern Taiwan who tested positive for the fungus following a skin infection, he said.
The man had diabetes and pemphigus, and regularly took prescription steroids and antibiotics, Lo said.
In May 2021, a Taiwanese businessman in his 60s who had returned from Vietnam to get treatment for septic encephalopathy tested positive for the fungus, Lo said, adding that it was the only time a candidiasis case in Taiwan was deemed life-threatening.
The man recovered after receiving intravenous antifungal medication, he said.
The most recent case, reported in February last year, was a resident of southern Taiwan in his 40s, Lo said.
The man tested positive after developing an ear infection with symptoms including discharge from the ear, tinnitus, hearing loss and vertigo, Lo said.
As candidiasis is not recognized as an epidemic, hospitals are not obliged to report infections, potentially leading to cases being unreported, he said.
The fungus can survive on surfaces for weeks, and many of its strains are resistant to multiple types of antifungal drugs, including some that are resistant to all three major groups of medication used to treat candidiasis, Lo said.
Traces of the fungus have been detected in the respiratory systems, urinary tracts and inner organs of healthy people, he said.
The CDC did not identify the infection source of the three Taiwanese cases, Lo added.

Taiwan has arranged for about 8 million barrels of crude oil, or about one-third of its monthly needs, to be shipped from the Red Sea this month to bypass the Strait of Hormuz and ease domestic supply pressures, CPC Corp, Taiwan (CPC, 台灣中油) said yesterday. The state-run oil company has worked with Middle Eastern suppliers to secure routes other than the Strait of Hormuz, through which about 20 percent of the world’s oil and liquefied natural gas typically passes, CPC chairman Fang Jeng-zen (方振仁) said at a meeting of the legislature’s Economics Committee in Taipei. Suppliers in Saudi Arabia have indicated they

South Korea has adjusted its electronic arrival card system to no longer list Taiwan as a part of China, a move that the Ministry of Foreign Affairs said would help facilitate exchanges between the two sides. South Korea previously listed “Taiwan” as “Taiwan (China)” in the drop-down menus of its online arrival card system, where people had to fill out where they came from and their next destination. The ministry had requested South Korea make a revision and said it would change South Korea’s name on Taiwan’s online immigration system from “Republic of Korea” to “Korea (South),” should the issue not be

CCP ‘PAWN’? Beijing could use the KMT chairwoman’s visit to signal to the world that many people in Taiwan support the ‘one China’ principle, an academic said Chinese Nationalist Party (KMT) Chairwoman Cheng Li-wun (鄭麗文) yesterday arrived in China for a “peace” mission and potential meeting with Chinese President Xi Jinping (習近平), while a Taiwanese minister detailed the number of Chinese warships currently deployed around the nation. Cheng is visiting at a time of increased Chinese military pressure on Taiwan, as the opposition-dominated Legislative Yuan stalls a government plan for US$40 billion in extra defense spending. Speaking to reporters before going to the airport, Cheng said she was going on a “historic journey for peace,” but added that some people felt uneasy about her trip. “If you truly love Taiwan,

A global survey showed that 60 percent of Taiwanese had attained higher education, second only to Canada, the Ministry of the Interior said. Taiwan easily surpassed the global average of 43 percent and ranked ahead of major economies, including Japan, South Korea and the US, data from the Organisation for Economic Co-operation and Development (OECD) for 2024 showed. Taiwan has a high literacy rate, data released by the ministry showed. As of the end of last year, Taiwan had 20.617 million people aged 15 or older, accounting for 88.5 percent of the total population, with a literacy rate of 99.4 percent, the data